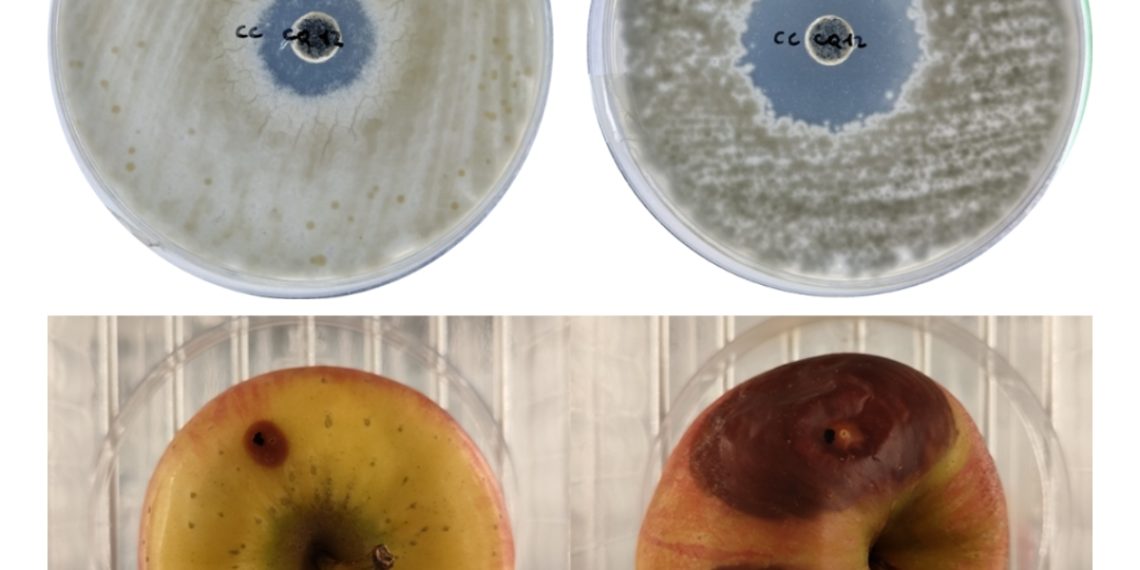
La Universitat de València convierte residuos del caqui en recubrimientos, conservantes y fertilizantes sostenibles con apoyo de la Conselleria de Innovación

La Conselleria de Innovación, Industria, Comercio y Turismo, bajo la dirección de Marián Cano, respalda un proyecto puntero que transforma los residuos del caqui en soluciones innovadoras para sectores clave como el agroalimentario, agrícola y farmacéutico.
Financiado a través de Ivace+i Innovación y cofinanciado por el programa FEDER de la Comunitat Valenciana (2021–2027), el proyecto KAKIVALUE liderado por el Laboratorio de Biotecnologías Alimentarias (BiotechLab) de la Universitat de València, se alza como un ejemplo de economía circular aplicada y ciencia con impacto.
El objetivo: revalorizar los restos generados por la industria del caqui mediante el desarrollo de ingredientes bioactivos con múltiples aplicaciones. Entre las más destacadas, un barniz antifúngico para frutas recolectadas que alarga su conservación postcosecha sin recurrir al plástico; un aditivo para quesos capaz de frenar la listeriosis; un conservante natural para pan con eficacia comparable al propinato de calcio; y un biofertilizante que mejora el rendimiento agrícola.
Además, KAKIVALUE se adentra en el campo de los nutracéuticos, explorando los beneficios de los compuestos del kaki para la salud intestinal. Se analizan sus propiedades prebióticas y probióticas, gracias a bacterias ácido-lácticas aisladas del propio fruto y empleadas en la fermentación de los residuos.
Los primeros ensayos son prometedores: los recubrimientos han logrado retrasar la aparición de hongos en frutas durante siete días y los resultados en quesos cumplen con los estándares sanitarios. También en panadería, el aditivo natural ha mostrado un comportamiento comparable al conservante sintético más utilizado.
En fase de escalado y validación, el proyecto avanza hacia su industrialización, con la colaboración del centro tecnológico Aimplas para el desarrollo de recubrimientos y de Fedacova para la transferencia al sector agroalimentario.